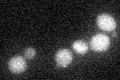
YGR154C
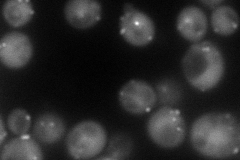
YGR154C
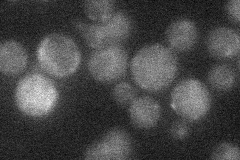
YGR154C
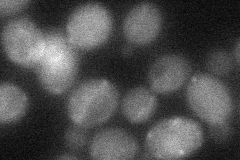
YGR154C
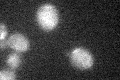
YGR154C

View description
Omega-class glutathione transferase; induced under oxidative stress; putative peroxisomal localization
Localization:
Intensity:
Fold change:
Significance:
-
C’ GFP library in SD
cytosol19.31 -
N' NOP1pr-GFP in SD
cytosol,punctate108.324 -
N' TEF2pr-mCherry in SD

cytosol,punctate175.831 -
N' NATIVEpr-GFP in SD
below threshold18.2352 -
N' TEF2pr-VC and Cyto-VN in SD
cytosol36.3298 -
C’ GFP library in SD+DTT

cytosolN/AN/ANo -
C’ GFP library in SD+H2O2
cytosol21.191.09No -
C’ GFP library in Starvation Media

cytosol26.31.36No -
C’ GFP library on the background of Pup2-DaMP

cytosol -
C’ GFP library on the background of CCT mutant

cytosol17.6760.914989No
